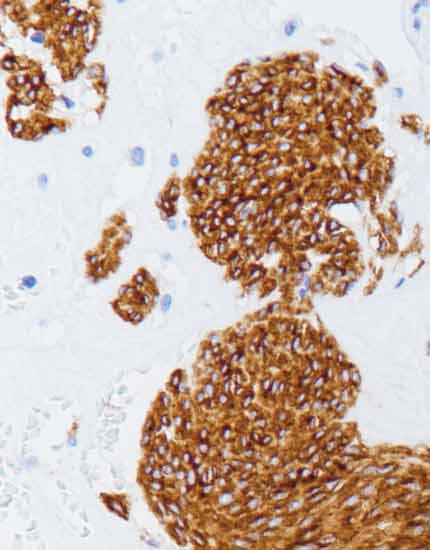

CD117(C-kit)是原癌基因4q11-q12编码的分子量为145~160kDa的III型跨膜蛋白酪氨酸激酶生长因子受体蛋白,也可称为肥大细胞生长因子。表达于肥大细胞、Cajal间质细胞、黑色素细胞和各种上皮细胞等。可联用CD34和DOG1用于胃肠道间质瘤的诊断,80~100%胃肠道间质瘤(GIST)CD117+。还可以用于鉴别淋巴瘤与肥大细胞肿瘤,亦可作为部分睾丸生殖细胞肿瘤的标记物。
CD117作为GIST免疫组化检查的特异性标记物,可用于临床指导GIST患者个性化的靶点药物(格列卫)治疗。
| 价格 | ||||||
| 规格 | 1.5ml | 3.0ml | 6.0ml | 0.1ml(浓缩) | 0.2ml(浓缩) | 阳性对照片(3片/盒) |
| 价格 | - | 812.00 | 1568.00 | - | - | 25.00 |